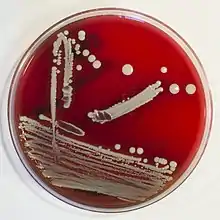

Staphylococcus condimenti
Staphylococcus condimenti is a Gram-positive, coagulase-negative member of the bacterial genus Staphylococcus consisting of single, paired, and clustered cocci. Strains of this species were originally isolated from fermenting soy sauce mash and are positive for catalase, urease, arginine dihydrolase, nitrate reductase, beta-galactosidase, and phosphatase activity.[1]
| Staphylococcus condimenti | |
|---|---|
![]() | |
| Staphylococcus condimenti colonies on Columbia sheep blood agar, colonies shown with reflected light (for detecting hemolysis transmitted light is recommended).
{ | |
| Scientific classification | |
| Domain: | Bacteria |
| Phylum: | Bacillota |
| Class: | Bacilli |
| Order: | Bacillales |
| Family: | Staphylococcaceae |
| Genus: | Staphylococcus |
| Species: | S. condimenti |
| Binomial name | |
| Staphylococcus condimenti Probst et al. 1998 | |
Unlike some clinical Staphylococcus isolates and some food-derived strains, S. condimenti has shown no noticeable resistance to antibiotics including lincomycin and penicillin.[2]
References
- Probst, AJ; Hertel, C; Richter, L; Wassill, L; Ludwig, W; Hammes, WP (July 1998). "Staphylococcus condimenti sp. nov., from soy sauce mash, and Staphylococcus carnosus (Schleifer and Fischer 1982) subsp. utilis subsp. nov". International Journal of Systematic Bacteriology. 48 (3): 651–8. doi:10.1099/00207713-48-3-651. PMID 9734019.
- Resch, M; Nagel, V; Hertel, C (Sep 30, 2008). "Antibiotic resistance of coagulase-negative staphylococci associated with food and used in starter cultures". International Journal of Food Microbiology. 127 (1–2): 99–104. doi:10.1016/j.ijfoodmicro.2008.06.013. PMID 18625535.
External links
This article is issued from Wikipedia. The text is licensed under Creative Commons - Attribution - Sharealike. Additional terms may apply for the media files.